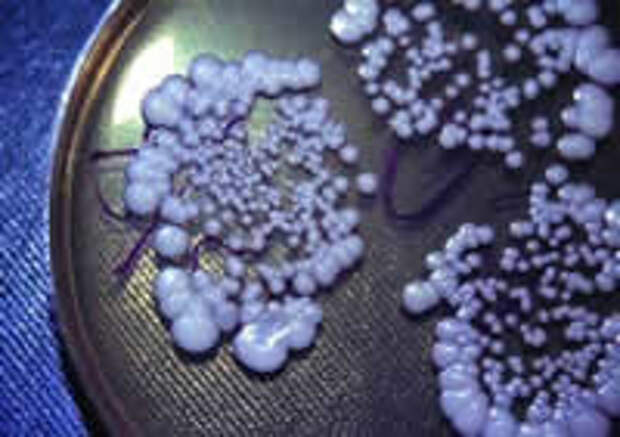

Возбудитель заболевания.
Возбудитель заболевания. Все о кандидозе и его.
Все о кандидозе и его. Все о молочнице у мужчин.
Все о молочнице у мужчин. Залаин против молочницы
Залаин против молочницы Залаин – современная защита
Залаин – современная защита Залаин, защитник от молочницы
Залаин, защитник от молочницы Зуд при молочнице
Зуд при молочнице Кандидоз
Кандидоз Кандидоз ротовой полости
Кандидоз ротовой полости Кандидоз у женщин
Кандидоз у женщин Кандидоз у мужчин
Кандидоз у мужчин Кандидоз – не только.
Кандидоз – не только. Кандидомикозный стоматит.
Кандидомикозный стоматит. Лечение кандидоза
Лечение кандидоза Лечение пищеводного кандидоза
Лечение пищеводного кандидоза Общие сведения о кандидозе
Общие сведения о кандидозе Опасные последствия кандидоза
Опасные последствия кандидоза Свечи от молочницы
Свечи от молочницы Симптомы кандидоза
Симптомы кандидоза Спрей ОРАЛСЕПТ ®
Спрей ОРАЛСЕПТ ® Что нужно знать о кандидозе?
Что нужно знать о кандидозе?
 Оглавление
Оглавлениенародные средства для спринцевания женщинам
- Причины заболевания
средство от комаров для детей от 1 года народным способом - Симптомы
как вывести лишай у ребенка народные средства - Лечение заболевания
что делать если защемило спину народными средствами - Вагинальные свечи, применяемые для лечения
ларингит пропал голос народные средства - Некоторые особенности вагинальных суппозиториев
тревога на душе без причины лечение народными средствами - У беременных
народное средство лечения грибка ногтей и стоп - У мужчин
народные средства повышения потенции и у - У детей
народное средство от шипиц на руке - Как применять суппозитории?
хронический геморрой лечение народным средством - Отзывы
всд народное средство Молочница – это инфекционное заболевание, причиной которого являются дрожжеподобные грибы Candida. Кандидозы характерны тем, что на слизистых оболочках, которые поражаются грибками, нарушается естественная микрофлора.
Причины молочницы
народные средства от полипа эндометрия в матке Грибки часто находятся в неактивном состоянии в нашем организме, и становятся активными тогда, когда сопротивляемость организма снижается. В категорию риска входят:
что пить при анемии из народных средств • Беременные.
осложнение после гриппа народными средствами • Диабетики.
рецепты народных средств от выпадения волос для • Люди, которые недавно перенесли какое-либо инфекционное заболевание.
лечение от цистита народными средствами в домашних условиях • Люди с нарушенным гормональным балансом. народные средства при упадки сил
Симптомы
лечение желтой кисты народными средствами Основные проявления кандидоза – зуд и жжение в пораженных грибком местах, интенсивные выделения (бели) из влагалища. А также:
народное средство при понижение сахара • Так называемый «рыбный» запах, весьма неприятный, усиливающийся после коитуса.
хорошее народное средство от геморроя • Болезненность полового акта (при введении во влагалище полового члена).
народное средство для похудения живота и бока • Боль при мочеиспускании.
Ощущение зуда может усиливаться после ходьбы, после банных процедур, во время менструаций. Выделения могут иметь разную консистенцию (мажущиеся, творожистые, жидкие), и разный цвет (белый, зеленоватый). Болезнь протекает в острой и хронической формах. Острую форму вылечить гораздо легче; её симптоматика ярко выражена. Симптомы хронической формы настолько стёрты, что пациентки просто привыкают к несильному ощущению зуда и не обращают на него внимание. Хроническую форму сложнее излечить.
народные средства вызывающие аппетитЖелательно, чтобы не возникло повторного заражения кандидами, провести параллельное лечение своего полового партнера.
народные средства избавления от похмелья
 Говоря об этом заболевании, как-то больше приходит на ум вагинальный. Но оказывается, мужчины тоже страдают этим недугом. Как проявляется это заболевание, и каким образом оно лечится? Подробнее о проявлениях этой болезни у мужчин Вы узнаете из нашей статьи.
Говоря об этом заболевании, как-то больше приходит на ум вагинальный. Но оказывается, мужчины тоже страдают этим недугом. Как проявляется это заболевание, и каким образом оно лечится? Подробнее о проявлениях этой болезни у мужчин Вы узнаете из нашей статьи.
чем повышают иммунитет народными средствами Данное заболевание у мужчин может быть как эндогенного происхождения, так и экзогенного. В первом случае происходит бесконтрольное размножение кандид, которые уже населяют организм мужчины. А во втором, кандиды в больших количествах заносятся во время полового акта с больной партнершей. Необходимо сказать, что при любом способе заболевания у мужчин, решающую роль играет все-таки пониженная сопротивляемость организма.

бросить пить навсегда народными средствами за 2 недели Общие сведения
народное средство от усов у девушек Более 90% всех женщин когда-либо страдали от симптомов такого заболевания как молочница. Заболевание развивается из-за грибков рода Candida, в большом количестве скопившихся на слизистой оболочке вагины. Как правило, обширное распространение грибковой инфекции происходит тогда, когда иммунная система организма ослаблена.
Терапия в основном медикаментозная (специальные вагинальные свечи и таблетки), но также могут быть применены и народные методы. Обычно подобные способы лечения молочницы являются достаточно эффективными, однако у некоторых пациенток болезнь часто рецидивирует и к тому же их мучает постоянный зуд во влагалище, который не устраняют обычные свечи и таблетки.
маски для лечения волос народные средстваСимптомы
лечение возрастных прыщей народными средствами Заболевание характеризуется двумя основными клиническими проявлениями: зудом вагинальной области и усиленными выделениями белого или кремового цвета, имеющими творожистую консистенцию. Слизистая при выраженной молочнице выглядит покрасневшей; появляется боль в области влагалищного входа.
В редких случаях молочница может самостоятельно излечиться. Но чаще всего для успешной терапии приходится прибегнуть к специальным противогрибковым препаратам. Правда, большинство из них не могут устранить зуд, а ведь именно на него больше всего жалуются женщины. Этот раздражающий фактор приводит к сильному дискомфорту. Поэтому при назначении лечения нужно комбинировать противогрибковые препараты со средствами, устраняющими явления зуда.
народные средства базалиома
 Спрей Оралсепт - один из главных представителей антисептических спреев для горла и полости рта. Его главные достоинства - эффективность, удобство в применении (благодаря складывающейся насадке) и универсальность. Спрей оказывает комплексное действие: противовоспалительное, местное обезболивающее, антисептическое (против широкого спектра микроорганизмов) и противогрибковое. Достигается это в основном благодаря главному активному компоненту в составе Оралсепта, который называется бензидамина гидрохлорид. Это вещество относится к группе нестероидных противовоспалительных средств.
Спрей Оралсепт - один из главных представителей антисептических спреев для горла и полости рта. Его главные достоинства - эффективность, удобство в применении (благодаря складывающейся насадке) и универсальность. Спрей оказывает комплексное действие: противовоспалительное, местное обезболивающее, антисептическое (против широкого спектра микроорганизмов) и противогрибковое. Достигается это в основном благодаря главному активному компоненту в составе Оралсепта, который называется бензидамина гидрохлорид. Это вещество относится к группе нестероидных противовоспалительных средств.
катаракта лечение народными средствами с медом
 Кандидозы - являются следствием слабого иммунитета и организма в целом. Данное заболевание, чаще всего образуется из-за иммунодефицита. Это заболевание могут называть молочницей. Возникает в следствии большого развития дрожжеподобных грибов под названием - Сandida albicans. Симптомами кандидоза ротовой полости, являются выделения творожистого типа, белого цвета непосредственно на самой слизистой оболочки ротовой полости. Которые быстро исчезают, после употребления пищи либо споласкивания рта, после чего образуются ранки, которые болят и кровоточат на поверхности ротовой полости. Если болезнь прогрессирует, то в некоторых случаях может начаться распространение инфекции непосредственно на области неба, десен, а так же миндалин, гортани и даже на желудочно-кишечный тракт. Острый атрофический кандидоз, возникает в следствии очень длительного употребления антибиотиков - в качестве лечения какого - либо заболевания. Хронический атрофический кандидоз, образуется в следствии пользования зубными протезами. В данном случае, травмируется слизистая оболочка, которая имеет точку соприкосновения с протезом. Намного чаще, возникает из - за травмы нежных тканей, непосредственно самими протезами, которые плохо установлены. Это приводит к появлению хронического воспаления. Травмированная часть на слизистой оболочки имеет покраснение и даже отечность. Появляются болезненные ощущения, а так же жжение.
Кандидозы - являются следствием слабого иммунитета и организма в целом. Данное заболевание, чаще всего образуется из-за иммунодефицита. Это заболевание могут называть молочницей. Возникает в следствии большого развития дрожжеподобных грибов под названием - Сandida albicans. Симптомами кандидоза ротовой полости, являются выделения творожистого типа, белого цвета непосредственно на самой слизистой оболочки ротовой полости. Которые быстро исчезают, после употребления пищи либо споласкивания рта, после чего образуются ранки, которые болят и кровоточат на поверхности ротовой полости. Если болезнь прогрессирует, то в некоторых случаях может начаться распространение инфекции непосредственно на области неба, десен, а так же миндалин, гортани и даже на желудочно-кишечный тракт. Острый атрофический кандидоз, возникает в следствии очень длительного употребления антибиотиков - в качестве лечения какого - либо заболевания. Хронический атрофический кандидоз, образуется в следствии пользования зубными протезами. В данном случае, травмируется слизистая оболочка, которая имеет точку соприкосновения с протезом. Намного чаще, возникает из - за травмы нежных тканей, непосредственно самими протезами, которые плохо установлены. Это приводит к появлению хронического воспаления. Травмированная часть на слизистой оболочки имеет покраснение и даже отечность. Появляются болезненные ощущения, а так же жжение.
народные средства по лечению язвы желудка медом
 Весна наступает семимильными шагами, и вот уже дни становятся длиннее, воздух - теплее, вокруг поют птички, а из-под земли выползают первые ростки весенних цветов. Это означает, что настало время для того, чтобы радоваться новым сюрпризам и переменам. Однако не все перемены бывают приятными и приносятнам позитивные эмоции и ощущения.
Весна наступает семимильными шагами, и вот уже дни становятся длиннее, воздух - теплее, вокруг поют птички, а из-под земли выползают первые ростки весенних цветов. Это означает, что настало время для того, чтобы радоваться новым сюрпризам и переменам. Однако не все перемены бывают приятными и приносятнам позитивные эмоции и ощущения.
Поэтому если вдруг вы почувствовали, что у вас неожиданно появилась молочница, не следует сразу обращать гневные взгляды на своего возлюбленного и предъявлять ему обвинения в измене. Как говорила известная героиня фильма “Унесенные ветром”, - “Об этом я подумаю завтра!” А сегодня просто необходимо спокойно подвести итоги, отчего еще может начаться это неприятное заболевание.
испуг у ребенка лечение народными средствами
 В наше время существуют много препаратов, которые применяются для эффективного лечения кандидозного эзофагита. Но, независимо от большого выбора различных лекарств, лечение кандидоза пищевода проходит длительное время и требует большого внимания со стороны специалистов в данной области. Следует очень внимательно подбирать лекарственные препараты, так как есть лекарства, которые являются малоэффективными, а некоторые даже имеют тяжелые побочные эффекты. Помимо всего этого, повышается количество случаев резистентности к противогрибковым препаратам. При начальных стадиях лечения кандидоза пищевода, назначается пероральная терапия. Пациентам, с небольшим уровнем тяжести заболевания, а так же с низким уровнем нарушения иммунитета рекомендуется укороченный курс терапии с применением системных абсорбируемых медикаментозных препаратов, например - орального азола.
В наше время существуют много препаратов, которые применяются для эффективного лечения кандидозного эзофагита. Но, независимо от большого выбора различных лекарств, лечение кандидоза пищевода проходит длительное время и требует большого внимания со стороны специалистов в данной области. Следует очень внимательно подбирать лекарственные препараты, так как есть лекарства, которые являются малоэффективными, а некоторые даже имеют тяжелые побочные эффекты. Помимо всего этого, повышается количество случаев резистентности к противогрибковым препаратам. При начальных стадиях лечения кандидоза пищевода, назначается пероральная терапия. Пациентам, с небольшим уровнем тяжести заболевания, а так же с низким уровнем нарушения иммунитета рекомендуется укороченный курс терапии с применением системных абсорбируемых медикаментозных препаратов, например - орального азола.
народное средство от молочницы на языке Выбор современных лекарственных средств очень велик. При лечении пищеводного кандидоза рекомендуются противогрибковые средства нескольких групп. Самыми эффективными препаратами считаются препараты группы азола. Перорально рекомендуется применение не всасывающейся азолы, таких как; клотримазол, миконазол. Наиболее эффективными считаются лекарства системного воздействия таких групп как; кетоконазол, флуконазол, а так же итраконазол. Данные лекарственные препараты способствуют повреждению грибной клетки в следствии чего она умирает.
подтяжка кожи тела народными средствами
 Лечение кандидоза у женщин проходит с использованием различных медикаментов (таблеток, мазей, свечей). Особое внимание стоит уделить общему укреплению иммунитета. Необходимо принимать витамины. а так же употреблять в пищу как можно больше фруктов и овощей. Если вы страдаете легкой формой заболевания, которое поразило стенки влагалища, а так же наружные половые органы, то будет вполне эффективно местное лечение. Рекомендуется принимать такие препараты как; Клотримазол, Канизон, Кандибене, Канестен, Антифунгол, Йенамазол 100. Данные препараты зарекомендовали себя как эффективные средства в лечении кандидоза. Не стоит забывать, что консультация врача обязательна в выборе подходящего препарата для вас. Гино-травоген Овулум, Гинезол 7, Клион-Д 100, Тержинан. Изоконазол, Натамицин. Пимафуцин, Миконазол, Гино-дактарин, Полижинакс - так же являются эффективными средствами для борьбы с данным заболеванием. Очень эффективны такие препараты как Медофлюкон, Дифлюкан, Микосист, Форкан, Флюкостат, Дифлазон. Данные препараты помогут за короткое время избавиться от кандидоза. Дополнительно рекомендуется прохождение курса физиотерапии. иммунотерапии, общеукрепляющих препаратов. Существуют методы лечения кандидоза, которые вам могут предложить в качестве лечения. Например 5-10 процентный раствор буры в глицерине непосредственно во влагалище. Данный метод, в большинстве своем, не приносит положительного результата в лечении.
Лечение кандидоза у женщин проходит с использованием различных медикаментов (таблеток, мазей, свечей). Особое внимание стоит уделить общему укреплению иммунитета. Необходимо принимать витамины. а так же употреблять в пищу как можно больше фруктов и овощей. Если вы страдаете легкой формой заболевания, которое поразило стенки влагалища, а так же наружные половые органы, то будет вполне эффективно местное лечение. Рекомендуется принимать такие препараты как; Клотримазол, Канизон, Кандибене, Канестен, Антифунгол, Йенамазол 100. Данные препараты зарекомендовали себя как эффективные средства в лечении кандидоза. Не стоит забывать, что консультация врача обязательна в выборе подходящего препарата для вас. Гино-травоген Овулум, Гинезол 7, Клион-Д 100, Тержинан. Изоконазол, Натамицин. Пимафуцин, Миконазол, Гино-дактарин, Полижинакс - так же являются эффективными средствами для борьбы с данным заболеванием. Очень эффективны такие препараты как Медофлюкон, Дифлюкан, Микосист, Форкан, Флюкостат, Дифлазон. Данные препараты помогут за короткое время избавиться от кандидоза. Дополнительно рекомендуется прохождение курса физиотерапии. иммунотерапии, общеукрепляющих препаратов. Существуют методы лечения кандидоза, которые вам могут предложить в качестве лечения. Например 5-10 процентный раствор буры в глицерине непосредственно во влагалище. Данный метод, в большинстве своем, не приносит положительного результата в лечении.
лечение сосудистой гемангиомы народными средствами
 Кандидоз - это заболевание, которое является одним из наиболее распространённых инфекций. Возникает как у мужчин, так и у женщин. У детей, кандидоз ротовой полости встречается особенно часто в младенчестве, а так же в возрасте до 3 лет. Возбудителем данного заболевания являются грибы - Candida. Различают такие виды заболевания как: Candida albicans, Candida tropicalis, Candida krusei, Candida pseudotropicalis, Candida parapsilosis, Candida stellatoidea. Этот недуг поражает слизистые оболочки мочеполовых органов, ротовой полости, а так же носоглотки. Он может протекать в хронической форме, а в некоторых случаях возможны рецидивы. Симптомами этого заболевания или молочницы у женщин является воспаление влагалища, а так же наружных половых губ. Сопровождается болями во время полового акта, а так же зудом в данной области. Это заболевание может возникать на фоне уретрита, а так же цистита. Цистит является заболеванием мочевого пузыря, а так же его воспалением. У мужчин возникает заболевание - кандидозный баланопостит. Симптомами данного заболевания, является воспаление крайней плоти полового члена. В некоторых случаях может возникнуть заболевание - уретрит. Уретрит - заболевание мочеиспускательного канала (уретры). Простатит - так же может возникнуть в последствии неправильного лечения кандидоза. Поэтому, в случае возникновения симптомов данного заболевания, необходимо обратиться к специалисту, который поможет подобрать правильное лечение.
Кандидоз - это заболевание, которое является одним из наиболее распространённых инфекций. Возникает как у мужчин, так и у женщин. У детей, кандидоз ротовой полости встречается особенно часто в младенчестве, а так же в возрасте до 3 лет. Возбудителем данного заболевания являются грибы - Candida. Различают такие виды заболевания как: Candida albicans, Candida tropicalis, Candida krusei, Candida pseudotropicalis, Candida parapsilosis, Candida stellatoidea. Этот недуг поражает слизистые оболочки мочеполовых органов, ротовой полости, а так же носоглотки. Он может протекать в хронической форме, а в некоторых случаях возможны рецидивы. Симптомами этого заболевания или молочницы у женщин является воспаление влагалища, а так же наружных половых губ. Сопровождается болями во время полового акта, а так же зудом в данной области. Это заболевание может возникать на фоне уретрита, а так же цистита. Цистит является заболеванием мочевого пузыря, а так же его воспалением. У мужчин возникает заболевание - кандидозный баланопостит. Симптомами данного заболевания, является воспаление крайней плоти полового члена. В некоторых случаях может возникнуть заболевание - уретрит. Уретрит - заболевание мочеиспускательного канала (уретры). Простатит - так же может возникнуть в последствии неправильного лечения кандидоза. Поэтому, в случае возникновения симптомов данного заболевания, необходимо обратиться к специалисту, который поможет подобрать правильное лечение.
удалить нерв в зубе в домашних условиях народными средствами
 Кандидоз в народе называют - молочница. Заболевания грибкового происхождения типа Candida. Образуется на коже, а так же не слизистых оболочках. В основном данное заболевание поражает мочеполовые органы, а так же дыхательную, пищеварительную, нервную систему больного. Данное заболевание возникает в случае большого количества в организме грибов типа Candida. Candida - это грибы относящиеся к роду простейших, так как они являются - одноклеточными. Данный тип микроорганизмов является возбудителем кандидоза и довольна часто встречается в окружающем мире. Большое количество данных грибов являются - сапрофитами. Кандиды - не являются микроорганизмами вредными для здоровья человека. Они живут на коже любого из нас и не представляют для нашего здоровья никакой опасности в целом. В следствии какого - либо негативного фактора, в частности ослабление иммунитета. частые стрессы. лечение антибиотиками. Грибы вида Candida могут размножаться в большом количестве, что и является непосредствинным началом заболевания.
Кандидоз в народе называют - молочница. Заболевания грибкового происхождения типа Candida. Образуется на коже, а так же не слизистых оболочках. В основном данное заболевание поражает мочеполовые органы, а так же дыхательную, пищеварительную, нервную систему больного. Данное заболевание возникает в случае большого количества в организме грибов типа Candida. Candida - это грибы относящиеся к роду простейших, так как они являются - одноклеточными. Данный тип микроорганизмов является возбудителем кандидоза и довольна часто встречается в окружающем мире. Большое количество данных грибов являются - сапрофитами. Кандиды - не являются микроорганизмами вредными для здоровья человека. Они живут на коже любого из нас и не представляют для нашего здоровья никакой опасности в целом. В следствии какого - либо негативного фактора, в частности ослабление иммунитета. частые стрессы. лечение антибиотиками. Грибы вида Candida могут размножаться в большом количестве, что и является непосредствинным началом заболевания.
Науке известны около восьмидесяти различных видов данных грибов. Опасными для здоровья человека являются только десять из восьмидесяти, которые могут в некоторых случаях вызвать данное заболевание. Развитие кандидоза или молочницы, зависит на прямую от иммунной системы человека, которая либо борется с заболеваниями - либо нет. Поэтому важную роль в лечении играет укрепление организма различными витаминами .
 Заболевание, которое возникает в следствии обнаружения на слизистой оболочки повышенного количества микроорганизмов - Candida albicans, называется - Кандидоз. Стоит заметить, что в организме любого человека находятся грибы Candida, которые не приносят никакого вреда для здоровья человека. Опасность возникает в следствии того, что размножение данных грибов начинает стремительно расти. Данное заболевание может возникать в следствии применения антибиотиков. а так же контрацептивов, мазей и кремов. В большинстве случаев данное заболевание возникает вследствие какого-либо заболевания. Например после понижения иммунитета. Люди, страдающие сахарным диабетом. так же подвержены данным заболеванием. Не стоит забывать, что кандидоз может передаваться половым путем. У женщин данное заболевание поражает все половые органы (наружные половые органы и влагалище). У мужчин данное заболевание, в большинстве случаев, начинается с кандидозного уретрита. Инкубационный период заболевания, в среднем, длиться до двадцати дней. Первыми признаками данного заболевания является выделения белого цвета по утрам из половых органов, а так же боль во время мочеиспускания. На самочувствие кандидоз не влияет. Лечение заболевания начинают с определения причины, в следствии чего, возникло данное заболевание. Необходимо пройти ряд анализов, по выявлению точного диагноза. После консультации с доктором необходимо подобрать эффективное для вас лечение.
Заболевание, которое возникает в следствии обнаружения на слизистой оболочки повышенного количества микроорганизмов - Candida albicans, называется - Кандидоз. Стоит заметить, что в организме любого человека находятся грибы Candida, которые не приносят никакого вреда для здоровья человека. Опасность возникает в следствии того, что размножение данных грибов начинает стремительно расти. Данное заболевание может возникать в следствии применения антибиотиков. а так же контрацептивов, мазей и кремов. В большинстве случаев данное заболевание возникает вследствие какого-либо заболевания. Например после понижения иммунитета. Люди, страдающие сахарным диабетом. так же подвержены данным заболеванием. Не стоит забывать, что кандидоз может передаваться половым путем. У женщин данное заболевание поражает все половые органы (наружные половые органы и влагалище). У мужчин данное заболевание, в большинстве случаев, начинается с кандидозного уретрита. Инкубационный период заболевания, в среднем, длиться до двадцати дней. Первыми признаками данного заболевания является выделения белого цвета по утрам из половых органов, а так же боль во время мочеиспускания. На самочувствие кандидоз не влияет. Лечение заболевания начинают с определения причины, в следствии чего, возникло данное заболевание. Необходимо пройти ряд анализов, по выявлению точного диагноза. После консультации с доктором необходимо подобрать эффективное для вас лечение.
 Оказывается, у братьев наших меньших тоже бывает кандидоз. Например, у собак. У этих домашних животных это заболевание может вызвать выпадение шерсти или ухудшение ее вида, кожные болезни, аллергию. понос и даже болезни ушей.
Оказывается, у братьев наших меньших тоже бывает кандидоз. Например, у собак. У этих домашних животных это заболевание может вызвать выпадение шерсти или ухудшение ее вида, кожные болезни, аллергию. понос и даже болезни ушей.
Собака становиться вялой и много спит. В свободное от сна время собака постоянно чешет то одно место, то другое. Зуд может локализоваться в любой части тела животного. От того, что собака чешется и выгрызает кожу, у нее со временем появляются проплешины на шерсти. Кроме этого, кожа на пораженных местах теряет влагу, появляется подобие перхоти. она темнеет. Иногда кожа больного животного даже пахнет дрожжами.
Чаще кандидозом болеют те собаки, которых недавно пролечили курсом антибиотиков. Однако, даже плохая экологическая обстановка может способствовать развитию заболевания у четвероногого друга. Собаку могут пытаться лечить какими-либо препаратами, не поставив точного диагноза. На какое-то время это может снизить проявление заболевания, но только на время. Для того чтобы уничтожить в организме животного излишки кандид, не вводите в пищу животного углеводистые продукты, такие как крупы, хлеб и картофель. Не давайте животному антибиотики без особой необходимости. Давайте своей собаке препараты, которые способствуют нормализации кишечной микрофлоры. Это бифидуумбактерин и многие другие. Лечение собаки от кандидоза может занять много времени. Поэтому не ждите скорых результатов.
Сбалансируйте рацион своей собаки по витаминам и минералам. Для этого в ветаптеках продают специальные «собачьи» БАД (биологически активные добавки).
как избавиться от домашних муравьёв в квартире народными средствами Симптомами кандидоза у женщин являются выделения белого цвета, слизистой и творожистой консистенции с характерным запахом. Это заболевание сопровождается болями во время полового акта, болями при мочеиспускании, зудом, а так же жжением. Помимо всего этого, известны факты когда боль при половом акте является единственным признаком болезни. Симптомами наличия данного заболевания у мужчин является жжение, зуд в паховой области, появление небольших пузырьков на головке полового члена. Так же, возникает покраснение головки полового члена и непосредственно крайней плоти. По утрам, заметен белый налет на головке полового члена с характерным запахом. В некоторых случаях возможна боль при половом контакте, а так же боль до и после мочеиспускания. Самое печально то, что грибы вида Candidа по разному реагируют на противогрибковые препараты. Особенно трудно определить и назначить лечение в случае если кандидоз вызван несколькими видами различных грибов. Очень важно, чтобы вам правильно поставили диагноз. а так же назначили лечение, которое стало бы для вас эффективным. Не многие знают, что это заболевание в большинстве случаев передается половым путем, а так же может являться побочным эффектом какого либо фактора. Кандидоз может появиться после употребления антибиотиков. а так же гормональных средств. В случае дисбактериоза кишечника и влагалища. А так же если вы страдаете повешенным уровнем сахара крови (сахарным диабетом ).
Симптомами кандидоза у женщин являются выделения белого цвета, слизистой и творожистой консистенции с характерным запахом. Это заболевание сопровождается болями во время полового акта, болями при мочеиспускании, зудом, а так же жжением. Помимо всего этого, известны факты когда боль при половом акте является единственным признаком болезни. Симптомами наличия данного заболевания у мужчин является жжение, зуд в паховой области, появление небольших пузырьков на головке полового члена. Так же, возникает покраснение головки полового члена и непосредственно крайней плоти. По утрам, заметен белый налет на головке полового члена с характерным запахом. В некоторых случаях возможна боль при половом контакте, а так же боль до и после мочеиспускания. Самое печально то, что грибы вида Candidа по разному реагируют на противогрибковые препараты. Особенно трудно определить и назначить лечение в случае если кандидоз вызван несколькими видами различных грибов. Очень важно, чтобы вам правильно поставили диагноз. а так же назначили лечение, которое стало бы для вас эффективным. Не многие знают, что это заболевание в большинстве случаев передается половым путем, а так же может являться побочным эффектом какого либо фактора. Кандидоз может появиться после употребления антибиотиков. а так же гормональных средств. В случае дисбактериоза кишечника и влагалища. А так же если вы страдаете повешенным уровнем сахара крови (сахарным диабетом ).
 Кандидоз - заболевание возникающее в следствии общего ослабления организма, снижение иммунитета, после прохождения курса лечения с помощью антибиотиков, а так же передающиеся половым путем. Данное заболевание может встречаться как у мужчин, так и у женщин. Данное заболевание поражает не только половые органы, но и другие органы человеческого тела. Например ротовую полость и носоглотку. У мужчин и женщин данное заболевание проходит по разному. Например у женщин характерны такие симптомы как жжение, боль, зуд непосредственно в области промежности половых органов, наружных и малых половых губ, а так же влагалища, бело - желтые творожнообразные выделения, болевые ощущения при половом акте, болевые ощущения при мочеиспускании. Симптомами появления кандидоза у мужчин является боль, жжение, покраснение головки и крайней плоти полового члена. Признаком заболевания у мужчин, может стать белые выделения на головке полового члена с характерным запахом. Боль при половом сношении, болевые ощущения до и после мочеиспускании. Лечение кандидоза начинается с употребления противогрибковых препаратов (таблетки, мази, свечи). Общее укрепление организма, так же очень важно в лечении данного заболевания. Рекомендуется употребление витаминов повышающих иммунитет у больного, так как данное заболевания может возобновиться в следствии не устранённой первопричины болезни. Стоит заметить, что данное заболевание требует сравнительно продолжительного лечения.
Кандидоз - заболевание возникающее в следствии общего ослабления организма, снижение иммунитета, после прохождения курса лечения с помощью антибиотиков, а так же передающиеся половым путем. Данное заболевание может встречаться как у мужчин, так и у женщин. Данное заболевание поражает не только половые органы, но и другие органы человеческого тела. Например ротовую полость и носоглотку. У мужчин и женщин данное заболевание проходит по разному. Например у женщин характерны такие симптомы как жжение, боль, зуд непосредственно в области промежности половых органов, наружных и малых половых губ, а так же влагалища, бело - желтые творожнообразные выделения, болевые ощущения при половом акте, болевые ощущения при мочеиспускании. Симптомами появления кандидоза у мужчин является боль, жжение, покраснение головки и крайней плоти полового члена. Признаком заболевания у мужчин, может стать белые выделения на головке полового члена с характерным запахом. Боль при половом сношении, болевые ощущения до и после мочеиспускании. Лечение кандидоза начинается с употребления противогрибковых препаратов (таблетки, мази, свечи). Общее укрепление организма, так же очень важно в лечении данного заболевания. Рекомендуется употребление витаминов повышающих иммунитет у больного, так как данное заболевания может возобновиться в следствии не устранённой первопричины болезни. Стоит заметить, что данное заболевание требует сравнительно продолжительного лечения.
Свежие комментарии